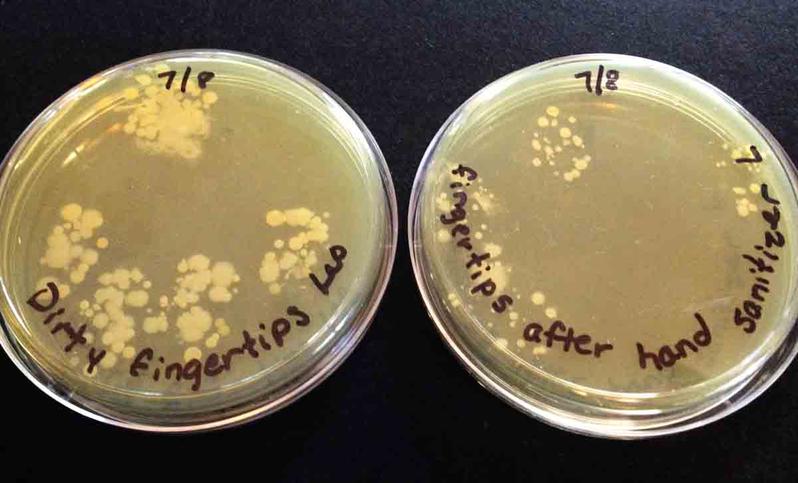

| ||||
How Well Does Alcohol-based Hand Sanitizer Kill Bacteria?
Experimental Methods and Results
HOUSEHOLD MICRO from Science Prof Online
As a microbiologist and a mom of two small children with allergies and asthma, I am always looking for ways to make our home and habits cleaner and healthier.
Like many parents, getting my children to do a good job washing their hands can be a struggle. Hand washing should involve lots of soap and rubbing, for at least 20 seconds. Hand sanitizers are a good back-up, a way to clean hands between washings.
Article Summary: Hand sanitizer is a useful microbial control option for when we are unable to wash with soap and water. Most claim to kill 99.9% "of common harmful germs and bacteria". But how well do hand sanitizers really work to clean hands?
How Well Does Hand Sanitizer Kill Bacteria? Experiment
 | ||||
You have free access to a large collection of materials used in a college-level introductory microbiology course. The Virtual Microbiology Classroom provides a wide range of free educational resources including PowerPoint Lectures, Study Guides, Review Questions and Practice Test Questions.
Page last updated: 2/2015
SCIENCE PHOTOS
SPO VIRTUAL CLASSROOMS
 | ||||||
 | ||||||
 | ||||||
ANOTHER HOME MICROBIOLOGY EXPERIMENT FROM SPO
Yes!
TSY agar with sample from dirty dishes on top (note bacterial colonies that grew), and sample from cleaned dishes on bottom.
experiment was repeated and the samples plated on TSY agar. The "before cleaning" floor sample is on the left (note numerous bacterial colonies) and the "after cleaning" sample on right.
 | ||||
Young children are natural born scientists, full of curiosity! Join the at-home experiments and explorations of a scientist mom & her kids.
 | ||||
SPO HOME SCIENCE PROJECT
BULLFROG METAMORPHOSIS
Currently we are raising bullfrog tadpoles and documenting their metamorphosis into adult frogs!
Click here to take a look!
Leo's Touch Plate Results: The photo on the left shows touch plates, viewed from the bottom, before (left plate) and after (right plate) use of hand sanitizer. The photo on the right shows the same plates viewed from the top. Each dot on the plates is a bacterial colony that grew from one sampled bacterium dividing so many times that the bacteria are now visible on the plate. Some colonies overlap, when several bacteria are sampled from the same area. Use of hand sanitizer clearly reduced the number and variety of microbes on Leo's fingertips.
Sophie's Touch Plate Results: The photo on the left shows Sophie's touch plates, viewed from the bottom, before (left plate) and after (right plate) use of hand sanitizer. The photo on the right shows the same plates viewed from the top. Her plates also show a variety in colony morphology (what bacterial colonies look like), and there are some small, round colonies, like Leo's plates showed, as well as some very large bacterial colonies. Note the very large colonies that spread out on the plate. Although these colonies are large, each still resulted from one bacterium in the original sample, and these large colony bacteria were certainly reduced by the hand sanitizer.
Touch Plate Experiment on the Effectiveness of Hand Sanitizer
In the college microbiology course I teach, we do a touch plate experiment that is notoriously unreliable, but still interesting and useful. By nature, this is a challenging experiment to control well. Because the sample is obtained by placing fingertips on a plate of TSY agar bacterial growth media, it's difficult to make sure the fingers touch the media in exactly the same way both before and after cleaning. If a slightly different area of the fingertips touch one plate compared with the other, entirely different bacteria can be introduced.
Also, since the body is covered with helpful normal flora, it is unlikely that any "after cleaning" sample will result in absolutely no bacterial growth. This experiment sometimes result in the "after cleaning" sample showing less bacteria growth, but more often results in fewer varieties of bacteria in the "after cleaning" sample (rather than fewer bacterial colonies), indicating that some bacteria are easier to destroy than others.
ATTENTION!: Please see the section on Safety Measures for Working with Live Bacteria
before attempting this experiment yourself!
Supplies Used
- 1 black permanent marker
- alcohol-based hand sanitizer
- 2 Petri dishes of TSY bacterial growth medium per person (a Bacteria Experiment Kit can be purchased from Home Science Tools for ~$30.)
Hand Sanitizer Trial #1
Experimental Methods
Cleaning Hands: My two children, Leo & Sophie did this experiment. I intended to have them use two pumps of hand sanitizer, rubbing it all over the hands until dry, and then touch nothing until the bacterial growth medium was touched. Here's how that rolled out in the real world:
Leo kept forgetting not to touch anything and put his hands on his shirt a couple of times. After each time he touched his shirt, I had him use a small amount of hand sanitizer to re-sanitize. So in total, he used two full pumps of hand sanitizer initially, and then two smaller pumps, each following touching his shirt.
Regarding Sophie, after one pump of hand sanitizer, she lost interest in the experiment and did not want to use anymore. She just wanted to finish. So she did not use as much hand sanitizer as Leo, and the results of her touch plate reflect this.
Obtaining Samples: Each child used the fingertips of one hand to gently touch the surface of a plate of TSY agar, one TSY plate was for dirty hands (before using sanitizer), another TSY plate was used for clean hands (after using sanitizer).
Storing Samples: The Petri plates were then stored in a warm location in the house, bottom side up, and observed for growth three days later.
Experimental Results Trial #1
Leo's Plates (pictured below) showed an excellent "textbook" example of the effectiveness of hand sanitizer in reducing the number of bacteria on his hands. Recall that he used extra hand sanitizer after touching his shirt a couple of times.
This page is part of a growing series of experiments we are doing on Microbiology In the Home. The experiment featured on this page tests the effectiveness of hand sanitizer in killing bacteria. To keep up on our latest results, check back frequently and Like Us on Facebook.
Adorable rhinovirus hand sanitizer or soap dispenser from Giant Microbes. In addition to having a couple of these in the home, I also usually buy a couple of these every year and give them to my kids' teachers to use in the classroom.
Sophie's plates (pictured below) certainly reflected a less effective use of hand sanitizer, but still did reduce the bacteria on her fingertips.
Hand Sanitizer Trial #2
Experimental Methods
Cleaning Hands: The kids used two pumps of hand sanitizer, rubbing it all over their hands until dry, and then touched nothing until the Petri plates were touched.
Obtaining Samples: Each child used the fingertips of one hand to gently touch the surface of a plate of TSY agar, one TSY plate was for dirty hands (before using sanitizer), another TSY plate was used for clean hands (after using sanitizer).
Storing Samples: The Petri plates were then stored in a warm location in the house, bottom side up, and observed for growth three days later.
Experimental Results Trial #2
Both photos below (left photo Leo's plates, right showing Sophie's plates) show a reduction in bacteria after using hand sanitizer.
Safety Measures When Working With Live Bacteria
Please read this section carefully before carrying out the experiment outlined above. Although these plates will be growing bacteria present on hands, once the bacteria begin growing on the agar plates, they will be present in much higher numbers than a person would normally encounter. Therefore, there are some important safety precautions to keep in mind:
- Wear safety goggles and protective gloves when handling plates that are growing bacteria.
- Never open the plates after placing the sample on the agar. Bacteria will be present in large numbers. Some can become airborne and be breathed in or land on areas of the body close to an open plate.
- Keep plates out of the reach of small children and pets.Talk to children about these safety precautions and make sure they know not to ever handle the plates without adult supervision.
- You may place a rubber band around the plates to reduce the likelihood that they will accidentally fall open.
- The top of the refrigerator can be a good place to store incubating plates, as it is up high and usually a bit warm.
- Placing incubating plates in open plastic bag (so aerobic bacteria can get oxygen) is a good measure to keep them safer and reduce odor (bacteria are stinky).
- When the experiment is finished, and you are done with the plates, place them in a zipped up plastic bag (Zip-loc) in the trash. They will run out of food and water eventually and die, but not before generating a lot of stink.
Leo's Touch Plate Results: The left photo above shows Leo's touch plates, viewed from the top, before (left plate) and after (right plate) use of hand sanitizer. A few things to note on the "after cleaning" plate: There is a very large colony growing across the bottom of the plate. There is a smaller, round colony growing within the bounds of the large colony. Also, Leo's fingernail went into the TSY agar on the bottom left side of the plate (Note red arrow). Because new bacteria may have been introduced from under his fingernail, this could have resulted in a wider variety of bacteria in this spot.
Sophie's Touch Plate Results: The right photo above shows Sophie's touch plates, viewed from the top, before (left plate) and after (right plate) use of hand sanitizer. There was a dramatic reduction in the number and variety of bacteria present after use of hand sanitizer. These plates also show some very large colonies, particularly on the right side of the plates.
<